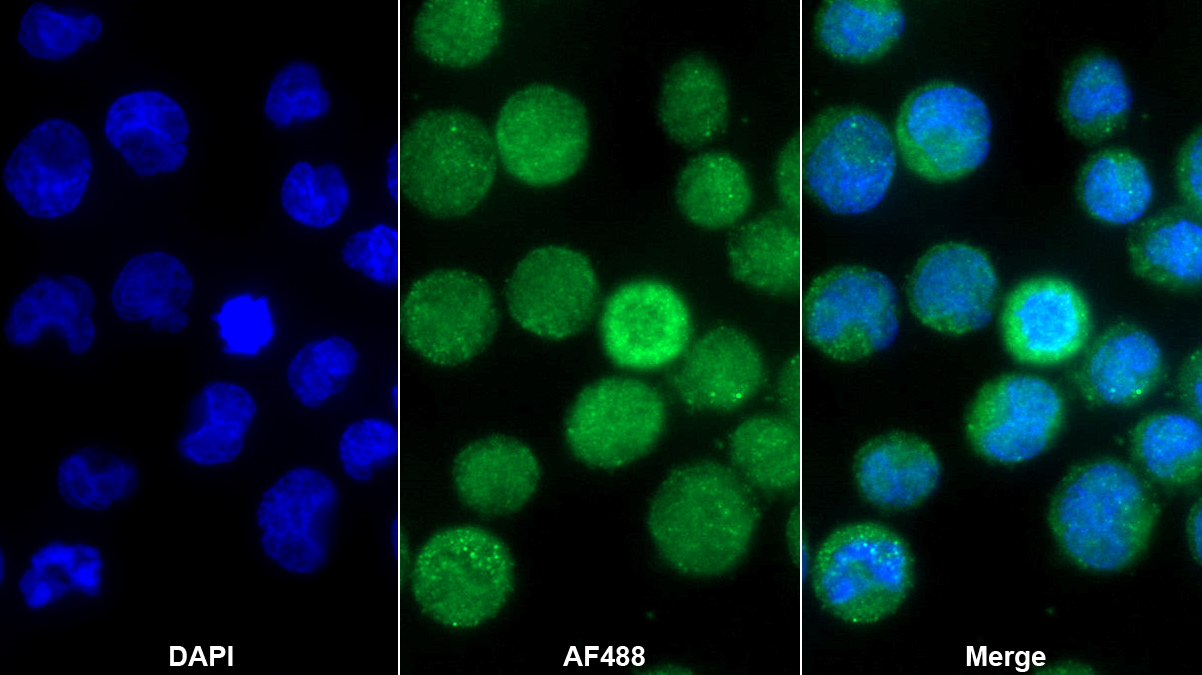

Polyclonal Antibody to Interleukin 8 (IL8) 

CXCL8; AMCF-I; GCP1; K60; LECT; LUCT; LYNAP; MDNCF; MONAP; NAF; NAP1; SCYB8; TSG1; B-ENAP; Neutrophil-Activating Protein 1; Granulocyte Chemotactic Protein 1
Overview
Properties
- Product No.PAA080Po01
- Organism SpeciesSus scrofa; Porcine (Pig) Same name, Different species.
- ApplicationsICC/IF
If the antibody is used in flow cytometry, please check FCM antibodies.
Research use only - DownloadInstruction Manual
- CategoryCytokineInfection immunity
- SourcePolyclonal antibody preparation, Host Rabbit
- Ig Type IgG, Potency n/a
- PurificationAntigen-specific affinity chromatography followed by Protein A affinity chromatography
- LabelNone
- Immunogen RPA080Po01-Recombinant Interleukin 8 (IL8)
- Buffer FormulationPBS, pH7.4, containing 0.02% NaN3, 50% glycerol.
- TraitsLiquid, Concentration 0.5mg/mL
Sign into your account
Share a new citation as an author
Upload your experimental result
Review

Contact us
Please fill in the blank.
Specifity
The antibody is a rabbit polyclonal antibody raised against IL8. It has been selected for its ability to recognize IL8 in immunohistochemical staining and western blotting.
Usage
Immunofluorescence: 5-20µg/mL;
Optimal working dilutions must be determined by end user.
Storage
Store at 4°C for frequent use. Stored at -20°C in a manual defrost freezer for two year without detectable loss of activity. Avoid repeated freeze-thaw cycles.
Stability
The thermal stability is described by the loss rate. The loss rate was determined by accelerated thermal degradation test, that is, incubate the protein at 37°C for 48h, and no obvious degradation and precipitation were observed. The loss rate is less than 5% within the expiration date under appropriate storage condition.
Organism Species More: Homo sapiens (Human)Giveaways
Increment services
-
 Antibody Labeling Customized Service
Antibody Labeling Customized Service
-
 Protein A/G Purification Column
Protein A/G Purification Column
-
 Staining Solution for Cells and Tissue
Staining Solution for Cells and Tissue
-
 Positive Control for Antibody
Positive Control for Antibody
-
 Tissue/Sections Customized Service
Tissue/Sections Customized Service
-
 Phosphorylated Antibody Customized Service
Phosphorylated Antibody Customized Service
-
 Western Blot (WB) Experiment Service
Western Blot (WB) Experiment Service
-
 Immunohistochemistry (IHC) Experiment Service
Immunohistochemistry (IHC) Experiment Service
-
 Immunocytochemistry (ICC) Experiment Service
Immunocytochemistry (ICC) Experiment Service
-
 Flow Cytometry (FCM) Experiment Service
Flow Cytometry (FCM) Experiment Service
-
 Immunoprecipitation (IP) Experiment Service
Immunoprecipitation (IP) Experiment Service
-
 Immunofluorescence (IF) Experiment Service
Immunofluorescence (IF) Experiment Service
-
 Buffer
Buffer
-
 DAB Chromogen Kit
DAB Chromogen Kit
-
 SABC Kit
SABC Kit
-
 Long-arm Biotin Labeling Kit
Long-arm Biotin Labeling Kit
-
 Real Time PCR Experimental Service
Real Time PCR Experimental Service
Citations
- Evidence that polymorphonuclear neutrophils infiltrate into the developing corpus luteum and promote angiogenesis with interleukin-8 in the cowRbej: 14777827
- Serial cytokine levels during wound healing in rabbit maxillary sinus mucosaPubMed: 19958244
- Experimental peri-implant mucositis at different implant surfaces.Pubmed: 24521508
- Budesonide added to modified porcine surfactant Curosurf may additionally improve the lung functions in meconium aspiration syndrome.Pubmed: 2432969
- Serum levels of selected chemokines in systemic lupus erythematosus patientsPubmed: 22461186
- Expression of interleukine-8 as an independent prognostic factor for sporadic colon cancer disseminationPubmed:Pmc4197484
- Experimental peri‐implant mucositis at different implant surfacesPubmed:24521508
- Grape seed extract supplementation attenuates the heat stress-induced responses of jejunum epithelial cells in Simmental?×?Qinchuan steersPubmed:24846452
- Inflammatory cytokine concentrations in uterine flush and serum samples from dairy cows with clinical or subclinical endometritisTheriojournal:Source
- Alteration in peripheral blood concentration of certain pro-inflammatory cytokines in cows developing retention of fetal membranesPubMed: 25851495
- ДИНАМИКА ЦИТОКИНОВОГО ПРОФИЛЯ В ОЦЕНКЕ ЭФФЕКТИВНОСТИ РАЗНЫХ МЕТОДОВ СТИМУЛЯЦИИ РЕПАРАТИВНОГО ОСТЕОГЕНЕЗА В ЭКСПЕРИМЕНТЕArticle: N
- Hyperinflation deteriorates arterial oxygenation and lung injury in a rabbit model of ARDS with repeated open endotracheal suctioningPubMed: 25943099
- Effects of different ventilation strategies on exhaled nitric oxide in geriatric abdominal surgeryPubMed: 25719610
- The Predictive Diagnostic and Prognostic Cut-off Values for Interleukin 8 in Patients with Meningitis in EgyptProfile: Mohmad_Mosaad
- Neutrophil gene dynamics and plasma cytokine levels in dairy cattle during peri-implantation periodPubmed:27090626
- Infection of chicken bone marrow mononuclear cells with subgroup J avian leukosis virus inhibits dendritic cell differentiation and alters cytokine expressionPubmed:27349993
- Perfusion of gastrodin in abdominal aorta for alleviating spinal cord ischemia reperfusion injuryscience:S1995764516300955
- Diabetes-induced renal failure is associated with tissue inflammation and neutrophil gelatinase-associated lipocalin: Effects of resveratrolpublication:299492265_Diabetes-induced_renal_failu
- Gln Attenuates LPS-induced Inflammatory Injury of Bos taurus Testis Sustentacular Cells10610
- Mutant DD genotype of NFKB1 gene is associated with the susceptibility and severity of coronary artery disease.pubmed:28088561
- Intravenous dexamethasone attenuated inflammation and influenced apoptosis of lung cells in an experimental model of acute lung injury.pubmed:28006948
- Mechanical Ventilation Alters the Development of Staphylococcus aureus Pneumonia in Rabbit.pubmed:27391952
- Effects of Conventional Mechanical Ventilation Performed by Two Neonatal Ventilators on the Lung Functions of Rabbits with Meconium-Induced Acute Lung Injuryacm.2017.16.issue-3
- Effects of budesonide on the lung functions, inflammation and apoptosis in a saline-lavagemodel of acute lung injury.pubmed:28195073
- 小剂量阿奇霉素对稳定期老年慢性阻塞性肺疾病患者外周血内TNF-α、IL-8、CRP水平及肺功能的影响Periodical_zgywjj201608004
- Cytokine levels in colostrum and in foals' serum pre- and post-sucklingpubmed:28242000
- Increased Chondrogenic Potential of Mesenchymal Cells From Adipose Tissue Versus Bone Marrow‐Derived Cells in Osteoarthritic In Vitro Modelspubmed:27739057
- Cardioprotective time-window of Penehyclidine hydrochloride postconditioning: A rat studypubmed:28684235
- Linezolid and atorvastatin impact on pneumonia caused by Staphyloccocus aureus in rabbits with or without mechanical ventilationpubmed:29149185
- The effect of restorative materials on cytokines in gingival crevicular fluidpubmed:28992599
- Experimentelle periimplantäre Mukositis an unterschiedlichen Implantatoberflächendoi: 10.1111/jcpe.12240.
- CagA promotes proliferation and inhibits apoptosis of GES-1 cells by upregulating TRAF1/4-1BBpubmed:28627614
- Dexamethasone reduces serum level of IL-17 in Bleomycin-A5-induced rats model of pulmonary fibrosispubmed:28608724
- Alteration in some pro and anti-inflammatory cytokines associated with complete and incomplete gestation cycle of cows10.1080/09291016.2017.1319636
- Optimization of Storage Temperature for Retention of Undifferentiated Cell Character of Cultured Human Epidermal Cell Sheetspubmed:28811665
- Inhibitory Effect of Low-Intensity Pulsed Ultrasound on the Expression of Lipopolysaccharide-Induced Inflammatory Factors in U937 Cells.pubmed:28600899
- Integrated effect of seasons and lactation stages on the plasma inflammatory cytokines, function and receptor expression of milk neutrophils in Sahiwal (Bos indicus) cows.pubmed:28895861
- Comparison of Polymyxin E and Polymyxin B as an Additive to Pulmonary Surfactant in Escherichia coli Pneumonia of Ventilated Neonatal Rabbits10.1159/000475877
- Association Between Endothelial Progenitor Cells and Treatment Response in Non-Squamous Non-small Cell Lung Cancer Treated with Bevacizumab.pubmed:28982871
- Inflammatory biomarkers and radiologic measurements in never-smokers with COPD: A cross-sectional study from the CODA cohort.pubmed:29117798
- Polar extract of protects cartilage homeostasis: possible mechanism of actionPubmed:29313174
- Dexmedetomidine attenuates renal fibrosis via α2-adrenergic receptor-dependent inhibition of cellular senescence after renal ischemia/reperfusionPubmed:29729264
- Pathogen-dependent modulation of milk neutrophils competence, plasma inflammatory cytokines and milk quality during intramammary infection of Sahiwal (Bos …Pubmed:29787791
- Evaluation of the therapeutic effect of micro-plasma radio frequency on hypertrophic scars in rabbit earsPubmed:30003425
- Rho Kinase Type 1 (ROCK1) Promotes Lipopolysaccharide-induced Inflammation in Corneal Epithelial Cells by Activating Toll-Like Receptor 4 (TLR4) …Pubmed:29804125
- Rifaximin anti‐inflammatory activity on bovine endometrium primary cell cultures: a preliminary studyPubmed:29984902
- N-Acetylcysteine inhalation improves pulmonary function in patients received Liver Transplantation.Doi: 10.1042/BSR20180858
- Effects of Conventional Mechanical Ventilation Performed by Two Neonatal Ventilators on the Lung Functions of Rabbits with Meconium-Induced Acute Lung …Doi: 10.1515/acm-2016-0012
- Metabolism and immune status during transition period influences the lactation performance in Zebu (Bos indicus () cowsPubmed: 17430930
- Interleukin 8 targeted contrast echocardiography is effective to evaluate myocardial ischemia-reperfusion injury in the rabbits
- Immunogenicity and protective efficacy against Treponema pallidum in New Zealand rabbits immunized with plasmid DNA encoding flagellinPubmed: 30405111
- The characteristics and clinical significance of mucin levels in bronchoalveolar lavage fluid of patients with interstitial lung diseasePubmed: 30573494
- Altered serum levels of type I collagen turnover indicators accompanied by IL-6 and IL-8 release in stable COPDPubmed: 30655663
- Chandrasekaran Chinampudur Velusami, Edwin Jothie Richard &
- Multiple myeloma-derived exosomes are enriched of amphiregulin (AREG) and activate the epidermal growth factor pathway in the bone microenvironment …Pubmed: 30621731
- Effective Treatment of Bovine Mastitis with Intramammary Infusion of Angelica dahurica and Rheum officinale Extracts
- Naoxintong Capsule Inhibits the Development of Cardiovascular Pathological Changes in Bama Minipig Through Improving Gut MicrobiotaPubmed: 31632272
- Anti-Inflammatory and Anti-Apoptotic Effects of Stybenpropol A on Human Umbilical Vein Endothelial CellsPubmed: 31671764
- Corrosion Resistance of Graphene oxide/Silver Coatings on Ni–Ti alloy and Expression of IL-6 and IL-8 in Human Oral FibroblastsPubmed: 32094428
- Suppressor of ras val-2 promotes inflammation-mediated oxidative stress and cell apoptosis in cardiomyocytes through activating Mst1-mROS signaling pathwayPubmed: 32065019
- Effects of Early Intervention with Antibiotics and Maternal Fecal Microbiota on Transcriptomic Profiling Ileal Mucusa in Neonatal PigsPubmed: 31963653
- Effect of Different Dosages of Dexamethasone Therapy on Lung Function and Inflammation in an Early Phase of Acute Respiratory Distress Syndrome ModelPubmed: 31928043
- Synthetic surfactant with a recombinant surfactant protein C analogue improves lung function and attenuates inflammation in a model of acute respiratory …Pubmed: 31694668
- Tectorigenin inhibits inflammation and pulmonary fibrosis in allergic asthma model of ovalbumin‐sensitized guinea pigsPubmed: 32314371
- Cyanidin-3-O-Glucoside Attenuates Lipopolysaccharide-Induced Inflammation in Human Corneal Epithelial Cells by Inducing Let-7b-5p-Mediated HMGA2/PI3K/Akt …Pubmed: 32248330
- NFKB1 gene rs28362491 ins/del variation is associated with higher susceptibility to myocardial infarction in a Chinese Han populationPubmed: 33177541
- Study on Adenovirus Infection in vitro with Nanoself-Assembling Peptide as Scaffolds for 3D CulturePubmed: 32922004
- A comparative study on various immunological parameters influencing embryo survivability in crossbred dairy cowsPubmed: 32810791
- SIRT1 relieves Necrotizing Enterocolitis through inactivation of Hypoxia-inducible factor (HIF)-1aPubmed: 32657204
- Hyperoside Protects Human Umbilical Vein Endothelial Cells Against Anticardiolipin Antibody-Induced Injury by Activating AutophagyPubmed: 32508661
- Peripheral concentrations of metabolic and inflammatory indicators during transition period and their relationship with postpartum clinical endometritis in dairy …
- Diet Supplementation with a Bioactive Pomace Extract from Olea europaea Partially Mitigates Negative Effects on Gut Health Arising from a Short-Term Fasting Period …
- Possible Anti-inflammatory Effects of Mesenchymal Stem Cells Transplantation via Changes in CXCL8 Levels in Patients with Refractory Rheumatoid Arthritis
- HMGB1 e citocinas inflamatórias em lesão pulmonar aguda experimental induzida em coelhos
- Inflammation Mediators Regulate the Microbiota Resistance to Adverse Factors33222085
- Impact of synthetic surfactant CHF5633 with SP©\B and SP©\C analogues on lung function and inflammation in rabbit model of acute respiratory distress syndrome33403805
- Cough Inhibition Activity of Schisandra chinensis in Guinea Pigs33861937
- Association between MIF gene promoter rs755622 and susceptibility to coronary artery disease and inflammatory cytokines in the Chinese Han population33850223
- Corrosion Resistance of Graphene oxide/Silver Coatings on Ni¨CTi alloy and Expression of IL-6 and IL-8 in Human O...32094428
- Response of broiler chickens fed diets supplemented with a bioactive olive pomace extract from Olea europaea to an experimental coccidial vaccine?¡33518110
- Construction of heparin-based hydrogel incorporated with Cu5. 4O ultrasmall nanozymes for wound healing and inflammation inhibition33778192
- Immunohistochemical Expression of Neurokinin-A and Interleukin-8 in the Bronchial Epithelium of Horses with Severe Equine Asthma Syndrome during Asymptomatic?¡34066204
- Talaromyces marneffei and nontuberculous mycobacteria co-infection in HIV-negative patients34376749
- Nitric-Oxide-Releasing Dexamethasone Derivative NCX-1005 Improves Lung Function and Attenuates Inflammation in Experimental Lavage-Induced ARDS34959373
- Exploring Epithelial–Mesenchymal Transition Signals in Endometriosis Diagnosis and In Vitro Fertilization Outcomes34829910
- Adverse Mechanical Ventilation and Pneumococcal Pneumonia Induce Immune and Mitochondrial Dysfunctions Mitigated by Mesenchymal Stem Cells in RabbitsPubmed:34965287
- Endometrial Dysbiosis Is Related to Inflammatory Factors in Women with Repeated Implantation Failure: A Pilot StudyPubmed:35566605
- Cell damage and neutrophils promote the infection of Mycoplasma pneumoniae and inflammatory responsePubmed:35724831
- LncRNA KCNQ10T1 shuttled by bone marrow mesenchymal stem cells-derived exosome inhibits sepsis via regulation of miR-154-3p/RNF19A axis
- Anti-inflammatory activity of non-selective PDE inhibitor aminophylline on the lung tissue and respiratory parameters in animal model of ARDS
- Evaluating the Roles of sCD14 and sCD14-ST in Diagnosing COPD and Predicting an Acute Exacerbation of COPD